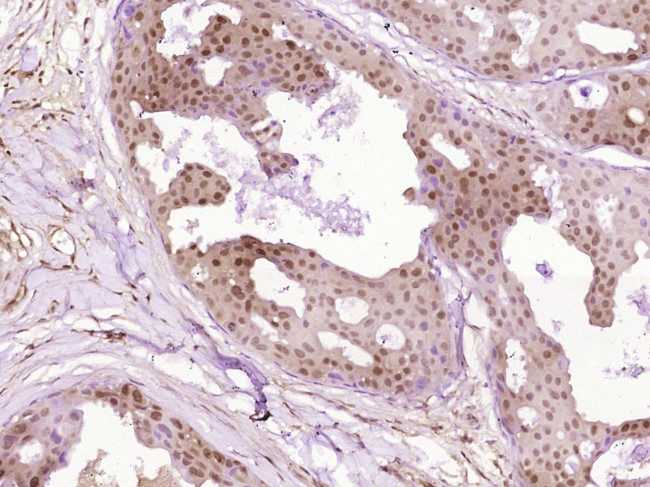
SNF2H Antibody in Immunohistochemistry (Paraffin) (IHC (P))

Search
Bioss
SNF2H Polyclonal Antibody
{{$productOrderCtrl.translations['antibody.pdp.commerceCard.promotion.promotions']}}
{{$productOrderCtrl.translations['antibody.pdp.commerceCard.promotion.viewpromo']}}
{{$productOrderCtrl.translations['antibody.pdp.commerceCard.promotion.promocode']}}: {{promo.promoCode}} {{promo.promoTitle}} {{promo.promoDescription}}. {{$productOrderCtrl.translations['antibody.pdp.commerceCard.promotion.learnmore']}}
图: 1 / 3
SNF2H Antibody (BS-12653R) in IHC (P)



产品信息
BS-12653R
种属反应
宿主/亚型
分类
类型
抗原
偶联物
形式
浓度
规格
纯化类型
保存液
内含物
保存条件
运输条件
靶标信息
SMARCA5 is a member of the SWI/SNF family of proteins. Members of this family have helicase and ATPase activities and are thought to regulate transcription of certain genes by altering the chromatin structure around those genes. SMARCA5 is a component of the chromatin remodeling and spacing factor RSF, a facilitator of the transcription of class II genes by RNA polymerase II. The protein encoded by this gene is a member of the SWI/SNF family of proteins. Members of this family have helicase and ATPase activities and are thought to regulate transcription of certain genes by altering the chromatin structure around those genes. The protein encoded by this gene is a component of the chromatin remodeling and spacing factor RSF, a facilitator of the transcription of class II genes by RNA polymerase II. The encoded protein is similar in sequence to the Drosophila ISWI chromatin remodeling protein.
仅用于科研。不用于诊断过程。未经明确授权不得转售。
篇参考文献 (0)
生物信息学
蛋白别名: hSNF2H; mSnf2h; SMARCA5; Sucrose nonfermenting protein 2 homolog; sucrose nonfermenting-like 5; SWI/SNF related, matrix associated, actin dependent regulator of chromatin, subfamily a, member 5; SWI/SNF-related matrix-associated actin-dependent regulator of chromatin A5; SWI/SNF-related matrix-associated actin-dependent regulator of chromatin subfamily A member 5; unnamed protein product
基因别名: 4933427E24Rik; D030040M08Rik; D330027N15Rik; hISWI; hSNF2H; ISWI; MommeD4; SMARCA5; SNF2H; WCRF135
UniProt ID: (Human) O60264, (Mouse) Q91ZW3
Entrez Gene ID: (Human) 8467, (Rat) 307766, (Mouse) 93762